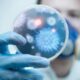

• este vorba despre o fetiţă de 6 ani din Brăila, care a fost vaccinată recent pentru imunizarea activă combinată împotriva difteriei, tetanosului, tusei convulsive şi...


• în primele 5 luni ale acestui an, medicii brăileni au comunicat 185 de cazuri de varicelă, o boală infecţioasă cunoscută şi sub denumirea populară de...


• Consiliul Judeţean a anunţat semnarea unui contract de reabilitare şi modernizare, în valoare de 1,5 milioane de euro • sursa de finanţare este asigurată, în...


• secţiile pavilioanelor A şi B din cadrul Spitalului Judeţean de Urgenţă Brăila prezintă adevărate pericole de infecţii pentru pacienţii internaţi • faianţa şi gresia căzute,...


• după ce în decembrie 2018, Serviciul de Ambulanţă Judeţean a primit 7 autospeciale noi de tip B, zilele trecute au mai sosit încă două salvări...


• deputatul PNL Brăila Antoneta Ioniţă a ajuns la concluzia că este incorect faptul că de la nivelul Casei Naţionale de Asigurări de Sănătate (CNAS) se...

• numai în primele 4 luni ale acestui an, spitalele din întreaga ţară au raportat peste 1.000 de cazuri, dintre care la Brăila figurează, oficial, 98...


• deşi au evitat, din răsputeri, pronunţarea focarului TBC, în lipsa unei conexiuni directe între cele 3 cazuri de TBC descoperite la şcoala nr. 5, Nikos...


• evenimentul a fost dedicat Zilei Copilului, sărbătorită anual la 1 Iunie Angajaţii Casei Judeţene de Asigurări de Sănătate Brăila au oferit cadouri copiilor care...


• banii vin prin transfer de la bugetul de stat la bugetul judeţului, prin intermediul Ministerului Sănătăţii • din această sumă, circa 9 milioane lei revin...